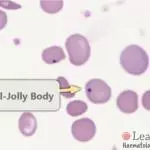

Haemoglobin SC disease is a sickling disorder which results from the co-inheritance of two abnormal ß globin genes, haemoglobin S and haemoglobin C (ßsßc). It is characterised by the presence of SC poikilocytes, abnormally contracted cells which resemble sickle cells but which have straight edges or are branched. The appearance of SC poikilocytes can be quite variable. The phenotypic severity of haemoglobin SC disease is variable; patients often have a higher steady-state haemoglobin that patients with ßsßs or ß0ßs.
Haemoglobin S arises from a point mutation in the ß globin gene. Sickle cell mutations are more common in individuals of African descent. They are also found in Central and South America, the Middle East and parts of India.
Haemoglobin C also arises from a point mutation in the the ß globin gene. The mutation is more common in West Africa, but can also be found in the Mediterranean and Caribbean regions.
Toolbar
Adjustments
Brightness
Contrast
Saturation


Blood film features:
- Mild-moderate microcytic, hypochromic anaemia
- SC poikilocytes – cells which have a variable appearance but are usually dense and may resemble sickle cells. They often have single or multiple angulated branches; some which resemble sickle cells may instead have straight edges. Classical SC poikilocytes may be quite rare, so they must be actively sought.
- Haemoglobin SC crystals – dense, irregularly-shaped crystals of haemoglobin in cells that appear to be otherwise devoid of haemoglobin. The crystals in haemoglobin C are more rhomboidal and regular in shape.
- Numerous boat cells – these often have an appearance of a boat viewed from the top, and are seen in many sickling disorders.
- Polychromasia
- Occasional sickle cells
- Occasional target cells
- Occasional nRBCs (not usually a prominent feature)
- May have features of hyposplenism
- Look for features of hydroxyurea therapy also
Cells seen in Haemoglobin SC Disease:
Differential diagnosis:
- Sickle cell anaemia (no SC poikilocytes, typically more sickle cells, no SC crystals or haemoglobin C crystals).
- Haemoglobin C disease (no SC poikilocytes, usually milder anaemia, haemoglobin C crystals with many target cells).
- Haemoglobin S / ß thalassaemia compound heterozygote (features of dyserythropoiesis suck as basophillic stippling and anisopoikilocytosis are more prominent, more target cells and nRBCs, no SC poikilocytes, no SC crystals).
- ß thalassaemia intermedia / major (no SC poikilocytes, SC crystals, sickle cells or boat-shaped cells. Features of dyserythropoiesis more prominent). The sickle test in ß thalassaemia intermedia / major is negative.
Other investigations:
- Sickle test: positive in Hb SC disease
- Haemoglobin electrophoresis
- HPLC
Haemoglobin electrophoresis:
Alkaline gel electrophoresis from a patient with haemoglobin SC disease. There are two variant haemoglobins, one with the mobility of haemoglobin S (red arrow) and the other with the mobility of haemoglobin C (blue arrow). The differentials for a band with the mobility of haemoglobin S are haemoglobins G, D and Lepore. The differentials for a band with the mobility of haemoglobin C are haemoglobins E, O-Arab and A2.

Acid gel electrophoresis from a patient with haemoglobin SC disease. There are two variant haemoglobins , one with the mobility of haemoglobin S (red arrow) and the other with the mobility of haemoglobin C (blue arrow). There is no normal haemoglobin A. This excludes haemoglobins G, D and Lepore as causes for the band at Hb S on the alkaline gel, as they have the mobility of Hb A on acid gel. Similarly, haemoglobins E and A2 have the mobility of haemoglobin A on acid gel and are hence excluded. Haemoglobin O-Arab has the mobility of haemoglobin S on acid gel.
HPLC:

HPLC from a patient with haemoglobin SC disease. There is no normal haemoglobin A. There are two variant haemoglobins with the retention times of haemoglobins S (red arrow) and C (blue arrow). This confirms the diagnosis of haemoglobin SC disease.
Other resources:
- ASH Image Bank: Haemoglobin SC Crystals
- PathPedia: Haemoglobin SC Disease
- Management of Haemoglobin SC Disease (BJH 2016)
- PHE Family Origin Questionnaire
- PHE Sickle Cell and Thalassaemia Screening Programme (2019)
- BCSH Guideline: Significant Haemoglobinopathies: Guidelines for Screening and Diagnosis (2010)
- BCSH Guideline: Management of Acute Chest Syndrome in SCD (2015)
- BCSH Guideline: Red Cell Transfusion in SCD Part I (2016)
- BCSH Guideline: Red Cell Transfusion in SCD Part II (2016)
- BCSH Guideline: Use of hydroxycarbamide in children and adults with SCD (2018)
- BCSH Guideline: Red blood cell specifications for patients with hemoglobinopathies: a systematic review and guideline (2020)
- RCOG Guideline: Management of SCD in Pregnancy (2011)

Hi Natasha! Can you share more about the images that don’t load? They seem to work fine for the pages you mentioned.